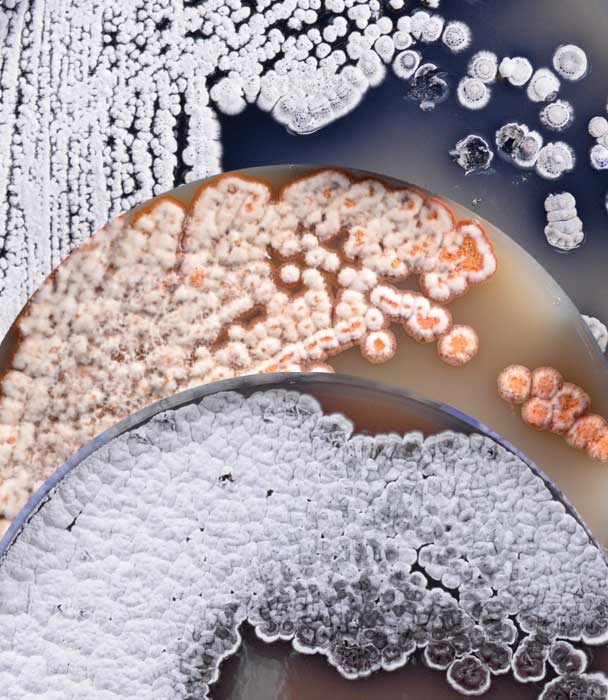
Biopigmenta

Bipigmenta
Inspiration Kaleidoscope
of colors
Sustainable,
Environmentally friendly,
Bioactive
Our world is a kaleidoscope of colors, a testament to nature's boundless creativity. From the deepest oceans to the highest mountains, vibrant hues paint every corner of our planet. However, the conventional color and dye industry often stands in stark contrast to this natural beauty, relying on unsustainable practices and harmful chemical synthesis that pollute our environment. Yet, a solution lies within the microscopic world. Bacteria, the most diverse group of organisms on Earth, hold an incredible, largely untapped potential. At Biopigmenta, we recognize that these remarkable microorganisms can be a source of stunning pigments. We are dedicated to utilizing bacteria to produce sustainable, environmentally friendly, bioactive, and beautiful dyes, offering a pathway to a more harmonious relationship between industry and nature.